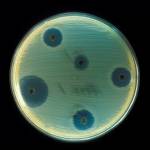

החללית שמצאה את הנחתת על המאדים

בשנת 2003 היה המאדים קרוב לכדור הארץ כפי שלא היה זה 60 אלף שנה. שתי אוניברסיטאות בריטיות, האוניברסיטה הפתוחה ואוניברסיטת לייסטר, ניצלו את ההזדמנות ושלחו נחתת בשם בייגל 2 (Beagle 2) על גבי חללית אירופאית בשם “אקספרס מאדים” (Mars Express) לשם חקר הביולוגיה והגיאולוגיה של פני שטח המאדים. בסוף שנת 2003 נחתה הנחתת על פני… המשך הקריאה